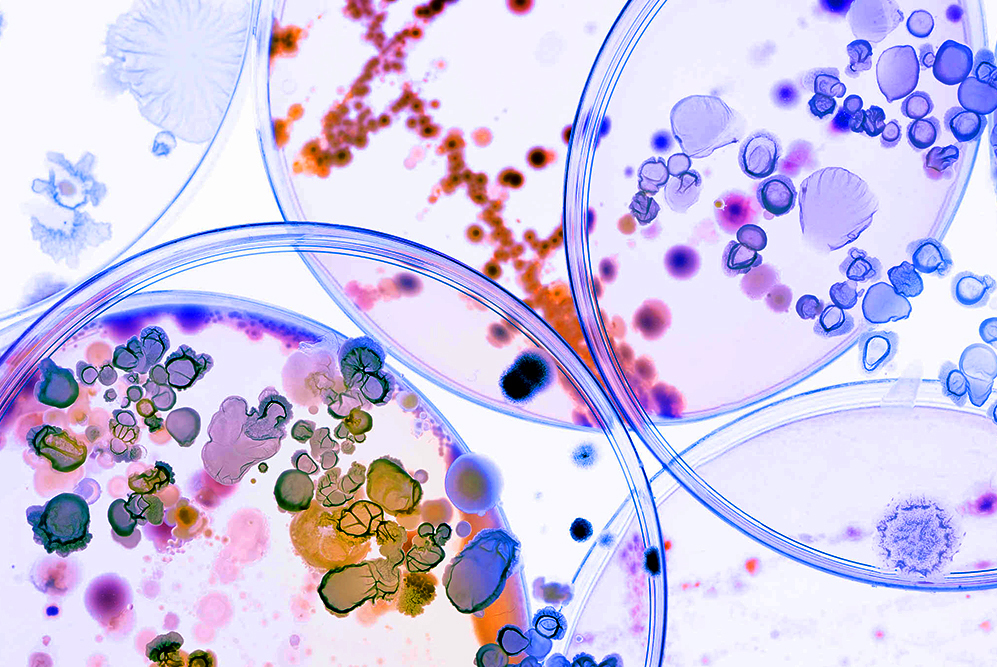

Где в нас живут бактерии и зачем они нам нужны?
 Отвечает Андрей Шестаков руководитель лаборатории микробной биотехнологии биологического факультета МГУ им. М. В. Ломоносова
Отвечает Андрей Шестаков руководитель лаборатории микробной биотехнологии биологического факультета МГУ им. М. В. Ломоносова
Число бактерий, живущих в нас, превышает число наших собственных клеток в десять раз. При этом существующая научная парадигма гласит, что плод стерилен. Первый контакт его с микроорганизмами происходит во время рождения — во время движения по родовым путям. И во время кормления ребенок приобретает первые микроорганизмы у себя в кишечнике. Становление тех микробов, которые потом сопровождают нас всю нашу жизнь, происходит примерно годам к четырем-пяти. При этом качество бактерий будет меняться в зависимости от рациона питания и с применением лекарств, например антибиотиков, которые убивают не только патогенную флору, но и хорошую. Взять новую хорошую, а главное, свою вам будет уже неоткуда.
Если представить, что клетки человеческого тела исчезнут, а бактерии останутся и их можно будет рассмотреть, то мы увидим внешний контур (кожу), кишечник — практически всю трубу от отверстия до отверстия — и начало половых путей, если мы говорим про женщину.
Бактерии человеку необходимы. Они, во-первых, греют, во-вторых — кормят, в-третьих — защищают. И даже действуют на наше поведение
Почему греют, а главное — как? Дело в том, что, когда организмы развиваются — в благополучной среде и с большой скоростью, — они выбрасывают большое количество тепла. Для примера: когда мы в колбе выращиваем микробов, если их совсем немного, мы их греем в термостате. А когда начинаем выращивать микроорганизмы в столитровых банках, их приходится регулярно охлаждать, добавляя холодную воду в «рубашку» и поддерживая таким образом нужную температуру.
Фото: Shutterstock.com
Фото: Shutterstock.com
Вот то же самое происходит и в кишечнике. Микробы там находятся в оптимальном состоянии: им очень хорошо, приятно, много еды. И они в ответ выделяют достаточно много тепла. Именно микробы снабжают нас энергией.
Кроме того, бактерии нас кормят. Наши человеческие клетки питаются тем, что им приносят микробы, процентов на 70. Именно они преобразуют остатки пищи, которую не смогли переварить желудок и тонкая кишка со своими ферментами. Так, белки и глюкозу мы усваиваем сразу, а вот углеводы, клетчатка — это все попадает в толстый кишечник.
И наконец, они нас защищают, держа нашу иммунную систему в постоянном напряжении.
Почему у человека именно по пять пальцев на руках и ногах?
Самый большой орган человека
Почему человек без ориентиров на местности ходит по кругу?